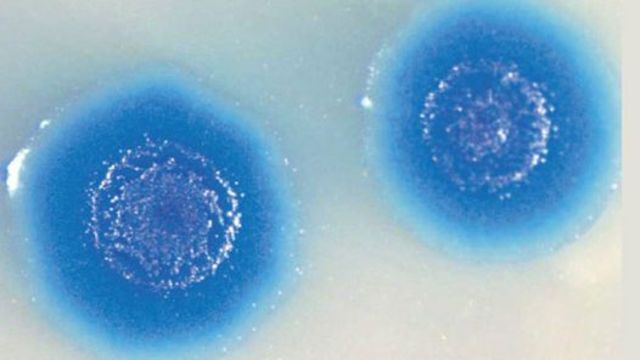
Primer Célula Sintética

-
Gregorio Mendel realiza experimentos cruzando plantas para comprobar a los genes como elementos responsables de la herencia.
-
Mendel publica sus experimentos de los cuales luego se derivan las leyes mendelianas de la herencia
-
Friedrich Meischer descubre una sustancia en el núcleo celular a la cual denomino como 'nucleína'.
-
Richard Altman separa por primera vez las proteínas de la 'nucleína', llamando a la nueva sustancia ácidos nucleicos.
-
William Bateson utiliza por primera vez el termino de 'Genética', para referirse a los estudios con respecto a herencia y cromosomas.
-
Phoebus Levene en sus estudios del ADN, demostró que este estaba formada por desoxirribosa, un grupo fosfato y cuatro bases nitrogenadas
-
Fred Griffith realiza experimentos que demostraron que bacterias no virulentas podían 'transformarse' en bacterias virulentas al estar en contacto con estas así estuvieran muertas. A esto lo llamo el 'principio transformador'.
-
Oswald Avery junto con Macleod y McCarty replican los experimentos de Griffith, para luego describir al ADN como el 'principio transformador' ya que era responsable de llevar la información genética necesaria para que las bacterias no virulentas se 'transformaran' en bacterias virulentas.
-
Rosalind Franklin tomo una imagen de difracción de rayos X del ADN extraordinariamente clara, a esta imagen se le conoció como la 'imagen 51', de la cual luego seria clave para el descubrimiento de la estructura del ADN.
-
Hershey y Chase realizan experimentos para apoyar la tesis de Avery sobre el ADN como el 'Principio Transformador' utilizando bacteriófagos para transformar el material genético de las bacterias.
-
Watson y Crick recolectaron datos de varios investigadores para ensamblar su célebre modelo de la estructura 3D del ADN, en el que se muestra a este con su doble hélice.
-
Meselson y Stahl realizan experimentos utilizando bacterias E.coli para determinar como los organismos replicaban su ADN, se tenían 3 modelos diferentes: Conservativo, Semiconservativo, y Dispersivo. De estos experimentos se concluyo que cada cadena de una molécula de ADN sirve como molde para la síntesis de una nueva cadena complementaria, lo que significa que el ADN es semiconservativo.
-
John Kendrew y Max Perutz desarrollaron una técnica de cristalografía de proteínas, que les permitió descifrar la estructura 3D de la hemoglobina y mioglobina.
-
Marshall Nirenberg junto con Ochoa y Khorana dirigieron una investigación en la cual identificaron los codones, la secuencia de tres unidades químicas del ADN, que recogen cada uno de los 20 aminoácidos que forman las moléculas de las proteínas, descifrando así el código genético.
-
Paul Berg experimenta con empalme de genes, de estos experimentos se prepara la primera molecula de ADN recombinante, es decir la primera 'clonación' exitosa.
-
Maxam y Gilbert desarrollaron un conjunto de métodos y técnicas que permitían secuenciar el ADN, basándose en el orden de los nucleótidos (A-T-G-C).
-
Frederick Sanger basándose en sus experimentos anteriores en el que descifro la secuencia de aminoácidos de la insulina, mejoro las técnicas para secuenciar al ADN creando el 'Método Sanger', basándose en la secuencia de didesoxinucleótidos.
-
El tribunal supremo acepta que se patenten organismos modificados genéticamente usando biotecnología.
-
Kary Mullis desarrollo una técnica de replicación del ADN, que permite la amplificación de secuencias especificas del ADN, al que llamo PCR (reacción en cadena de la polimerasa).
-
Se diagnostica por primera vez una enfermedad por ADN, reconstruyendo el genoma del feto a partir de un análisis de sangre de la madre.
-
En Europa, una década después de que se lograran transferir genes entre bacterias de diferentes especies, se logra hacer lo mismo entre plantas, creando la primera planta transgenica que fue un tabaco resistente al antibiótico camacina.
-
A partir de varias conferencias científicas surge la iniciativa de determinar la secuencia completa de nucleótidos del DNA humano e identificar y localizar los genes en los cromosomas.
-
Con la fundación del NCBI (National Center for Biotechnology Information), la bioinformática toma el control sobre los métodos para el análisis de datos biologicos.
-
Se crea la organización HUGO (Organización del Genoma Humano), para llevar a cabo el proyecto del genoma humano.
-
Diferentes científicos de Estados Unidos y México, publicaron en la revista 'science' la secuencia completa del genoma de la E.coli y la levadura.
-
En el Instituto Roslin de Edimburgo, en Escocia, de la mano de los científicos Ian Wilmut y Keith Campbell, se logro la primera clonación de la oveja 'dolly' a partir de una célula adulta.
-
Se publica la primera versión del genoma humano que localizaba a los genes dentro de los cromosomas.
-
Se publica la versión final del mapa genetico, completando así la primera fase del proyecto del genoma humano
-
El equipo del cientifico John Venter publicaron en la revista 'science', la creación de la primera celular sintética. Su genoma está copiado de un genoma natural, el de la bacteria Mycoplasma mycoides, pero ha sido sintetizado por métodos químicos.
-
Se crea el primer modelo computacional de una célula, que nos muestra completamente su estructura.
-
Investigadores del Nationwide Children’s Hospital han aplicado la terapia génica AAV9, suministrada vía intravenosa, para detener la atrofia muscular espinal tipo 1 (SMA1), la causa genética más común de muerte en bebés, salvando así,11 de los 12 bebes sometidos al ensayo clínico.
Plan projects on a visual timeline
Map milestones, phases, deadlines, and key events in one place so the sequence is easier to see and share. Timetoast is a timeline maker for work, school, research, and stories.